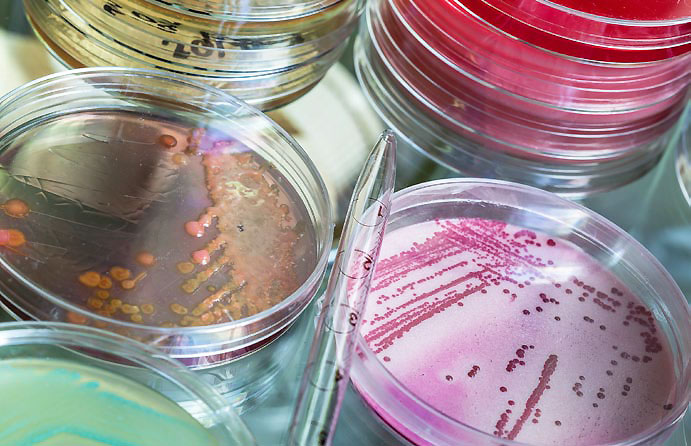
Antimikrobielle Peptide k&ouml;nnen dazu beitragen, Bakterien zu bek&auml;mpfen. Besonderes im Kampf gegen antibiotikaresistente Keime k&ouml;nnten sie hilfreich sein.

Infektionen sind weltweit immer noch eine der häufigsten Todesursachen. Dazu tragen die zunehmend multiresistenten Keime bei. Gegen sie könnten künftig aus Insekten isolierte Wirkstoffe helfen. Sie wurden weiterentwickelt und nun erfolgreich getestet.

Die Honigbiene (oben) und auch die Milchkrautwanze (unten) bilden antimikrobielle Peptide.
oben Ludmila Smite_thinkstock;unten Cathy Keifer_thinkstock
Josephine hatte vor einem Jahr eine Knieoperation. Ein unkomplizierter Eingriff, kein Grund zur Sorge, sagten die Ärzte. Stimmte eigentlich auch, denn die OP verlief reibungslos. Doch dann entzündete sich die Wunde. Mehrere Antibiotika-Therapien halfen nicht, und Josephines Zustand verschlechterte sich. Es wurde ernst – beinahe hätte die ambitionierte Hobbyläuferin das linke Bein verloren. Doch dann schlug ein Antibiotikum an, sprichwörtlich im letzten Moment. So schaurig dieses Fallbeispiel auch sein mag, ungewöhnlich ist es nicht. In Deutschland erleiden jedes Jahr schätzungsweise eine halbe Million Menschen eine Krankenhausinfektion durch bakterielle oder virale Erreger. Bis zu 15.000 Menschen sterben an diesen Infektionen. Bakterielle Krankenhausinfektionen gelten als besonders gefährlich, weil die verantwortlichen Keime oftmals multiresistent sind. Das bedeutet, dass sie mit Antibiotika nicht oder nur schwer zu behandeln sind. Sie sind resistent. Infektionen durch multiresistente Erreger nehmen aber auch außerhalb der Krankenhäuser zu. Seit Jahren steigen die Fallzahlen stetig. „Seit mehreren Jahrzehnten stehen der immer schneller zunehmenden Entwicklung von Antibiotikaresistenzen und den steigenden Fallzahlen leider keine Antibiotika gegenüber“, erklärt Professor Ralf Hoffmann, Chemiker an der Universität Leipzig.
Bienen und Wanzen liefern neue Wirkstoffe
Hoffmann forscht an neuen Wirkstoffen gegen Mikroorganismen. Dabei nehmen er und seine Kolleginnen und Kollegen insbesondere Insekten unter die Lupe. Ihr Interesse gilt den „antimikrobiellen Peptiden“ aus der Honigbiene und der Milchkrautwanze. Das sind kleine Proteine, genannt Peptide, die im Körper der Insekten produziert werden und auf eingedrungene Krankheitskeime reagieren. Hoffmann erklärt: „Antimikrobielle Peptide kommen nicht nur in Insekten vor. Insekten besitzen aber ein viel einfacheres Immunsystem als beispielsweise wir Menschen. Sie sind im Kampf gegen Krankheitskeime ausschließlich auf antimikrobielle Peptide angewiesen, daher finden wir hier eine besondere Vielfalt.“ Antimikrobielle Peptide können das Wachstum von Mikroorganismen hemmen oder sie sogar ganz abtöten. Diese Fähigkeiten machen sie natürlich auch pharmazeutisch interessant. Das Team aus Leipzig arbeitet daher direkt mit der Industrie zusammen. In einem vom Bundesministerium für Bildung und Forschung (BMBF) geförderten Projekt ist auch die AMP-Therapeutics GmbH involviert. „Wir konzentrieren uns auf antimikrobielle Peptide, die sich in Laborversuchen als besonders vielversprechende Kandidaten erwiesen haben. Diese wollen wir pharmazeutisch nutzbar machen“, erklärt Dr. Knut Adermann, wissenschaftlicher Leiter des Unternehmens. Eine solche Aufgabenteilung macht durchaus Sinn. Die Wissenschaftlerinnen und Wissenschaftler der Universität Leipzig konzentrieren sich darauf, die Wirkmechanismen der Peptide besser zu verstehen. Gleichzeitig übernimmt der Industriepartner die aufwendige und teure pharmazeutische Entwicklung ausgewählter Peptide.
Erste Ergebnisse sind vielversprechend
Zwei Klassen antimikrobieller Peptide interessieren das Forschungstandem derzeit besonders: das Apidaecin aus der Honigbiene und das Oncocin aus der Milchkrautwanze. „Wir konnten anhand dieser beiden Peptide einen neuen Wirkmechanismus identifizieren und kürzlich publizieren, der im Kampf gegen Krankheitskeime besonders effizient zu sein scheint“, fasst Hoffmann zusammen. Dies bestätigte sich auch bei den anschließenden präklinischen Tests in Mäusen. „Wir haben die Wirkung der antimikrobiellen Peptide bei unterschiedlichen bakteriellen Infektionen untersucht, beispielsweise bei Harnwegsinfektionen oder Abszessen. Auch die Wirksamkeit bei einer schweren systemischen Infektion, etwa einer Sepsis, haben wir angeschaut“, erläutert Adermann. „In allen Fällen waren die Ergebnisse äußerst vielversprechend.“
Antimikrobielle Peptide können dazu beitragen, Bakterien zu bekämpfen. Besonderes im Kampf gegen antibiotikaresistente Keime könnten sie hilfreich sein.
KatarzynaBialasiewicz_thinkstock
Neuen Resistenzen vorbeugen
Trotz dieser ermutigenden Zwischenergebnisse sind die Wissenschaftlerinnen und Wissenschaftler noch lange nicht am Ziel. „Wir haben bei unserem Verständnis zu den Wirkmechanismen der antimikrobiellen Peptide einen wichtigen Schritt vorwärts gemacht. Trotzdem müssen wir hier am Ball bleiben und noch tiefer in das Verständnis einsteigen“, erklärt der Leipziger Professor. Der Grund: Krankheitserreger können auch gegen solche Peptide Resistenzen ausbilden, genau wie gegen klassische Antibiotika. Will man dem entgegenwirken, ist es wichtig, die Wirkmechanismen der Peptide und die Resistenzmechanismen der Krankheitserreger genau zu verstehen. „Durch chemische Modifikation der Peptide können wir bereits mögliche Resistenzentwicklungen gezielt umgehen und eine breitere Wirksamkeit der neuen Wirkstoffe erreichen“, resümiert Hoffmann. Aber auch aus Sicht der Produktentwickler sind solche Informationen wichtig. Adermann erklärt: „Dieses Wissen benötigen wir, um die Wirksamkeit der Peptide weiter verbessern zu können. Oder auch, um den Abbau der Peptide im Organismus zu verzögern, damit sie länger wirksam sind.“
Die Forschungsergebnisse sollen zukünftig helfen, das steigende Niveau der Antibiotikaresistenzen wieder in den Griff zu bekommen. Das Beispiel von Josephine zeigt, wie dramatisch die Folgen einer Infektion mit multiresistenten Keimen sein können. Immerhin, für Josephine haben die behandelnden Ärzte ein wirksames Antibiotikum finden können: Die junge Frau ist mittlerweile wieder zu Hause und wird bald wieder joggen können.
Antimikrobielle Peptide kommen in praktisch allen Organismen vor: Tieren, Menschen und Pflanzen. Sie sind Teil des „angeborenen“ Immunsystems, sozusagen die Basisabwehr gegen Krankheitskeime. Ihre einzige Aufgabe ist es, Mikroorganismen abzutöten oder deren Wachstum zu blockieren, damit Infektionen sich nicht ausbreiten können. Das Interessante dabei ist, dass sogar Mikroorganismen selbst antimikrobielle Peptide produzieren – um das wichtige Gleichgewicht mit ihren Artgenossen aufrechtzuerhalten. Über 1.000 dieser Peptide sind bislang bekannt. Ganz neu ist das Interesse der Wissenschaft an diesen Peptiden nicht: Vor etwa einem Jahrzehnt galten sie als Hoffnungsträger bei den antimikrobiellen Wirkstoffen. Auf den Markt gekommen sind entsprechende Produkte bislang jedoch noch nicht. Heute, wo immer mehr Krankheitserreger gegen die klassischen Antibiotika resistent werden, müssen neue Strategien her – und die antimikrobiellen Peptide erleben sozusagen eine „Renaissance“.
Ansprechpartner:
Prof. Dr. Ralf Hoffmann
Biotechnologisch-Biomedizinisches Zentrum
Universität Leipzig
Deutscher Platz 5
04103 Leipzig
0341 97-31330
0341 97-31339
hoffmann@chemie.uni-leipzig.de